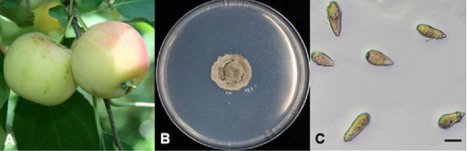

Le pommier commun (Malus pumila) est largement cultivé dans le nord de la Chine pour la production de gelées, de conserves et de cidre. En 2018, des symptômes atypiques de tavelure ont été observés dans la province chinoise de Heilongjiang. L'incidence de la maladie a été estimée à environ 0,4 %. Les symptômes se sont manifestés par des taches noires semblables à la tavelure, mais distinctes de celles causées par le Venturia inaequalis.
Les symptômes de la tavelure observés consistent en des taches noires claires de 3 à 5 mm sur la surface des fruits.
Les conidies étaient généralement produites sur des lésions, étaient cylindriques à fusiformes, 0 à 1 septé, jaunâtres et de taille 19,7 (13,5 à 25,8) × 5,7 (3,6 à 6,9) μm (n = 10). L'ADN de trois isolats sélectionnés a été extrait et séquencé.
Les scientifiques de l'Université agricole de Huazhong (Wuhan, Chine) ont constaté que les isolats testés étaient très proches du Venturia asperata. En juillet 2019, la pathogénicité de l'isolat VAHLJ3-1-1 a été évaluée sur le pommier commun. Une suspension de conidies d'une concentration de 5×105/ml a été pulvérisée uniformément sur la surface de six fruits. Afin de maintenir une humidité élevée, les fruits ont été enveloppés dans un sac plastique (une boule de coton contenant de l'eau a été placée dans le sac plastique) pour maintenir l'humidité pendant 3 jours. Six fruits pulvérisés avec de l'eau ont été utilisés comme témoins. Quatre semaines après l'inoculation, un symptôme similaire de tavelure atypique a été observé sur les fruits, et le V. asperata a été isolé de nouveau à partir de six fruits inoculés avec une fréquence de ré-isolation de 100 % par l'isolement d'une seule spore, alors qu'aucun symptôme n'a été observé sur les fruits témoins.
« Sur la base des identifications morphologiques et moléculaires, l'agent causal de cette tavelure atypique sur le pommier commun a été identifié comme étant le V. asperata. La tavelure du pommier est généralement causée par le V. inaequalis. Mais, la tavelure du pommier a également été causée par le V. asperata en Italie et en France. À notre connaissance, il s'agit du premier signalement de V. asperata associé à des lésions ressemblant à la tavelure du pommier en Chine. Cette information accroît nos connaissances sur le spectre des espèces de Venturia associées à la maladie sur les fruits du pommier et constituera une base précieuse pour étayer les stratégies de gestion de ce cultivar », concluent les scientifiques.
Source : Yang Zhou, Haidong Bu, Chingchai Chaisiri, Qin Tan, Li Wang, Liangfen Yin, Weixiao Yin, Chaoxi Luo, 'First Report of Atypical Scab Caused by Venturia asperata on Apple in China', 2021, Plant Disease.